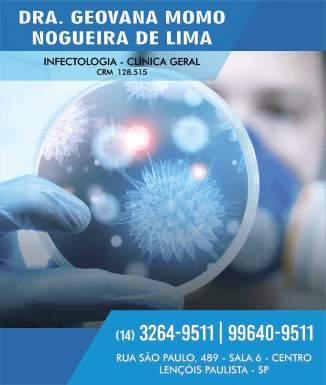

JANLARÊ







HÁ 12 ANOS OFERECE DIVERSIDADE EM FLORES E DECORAÇÃO RAINHA DA FACILPA ESTÁ CHEGANDO! INSCRIÇÕES ABREM NO PRÓXIMO DIA 13
TOXINA BOTULÍNICA
DR. JOÃO LUÍS GIL JORGE FALA SOBRE MITOS E VERDADES

JANLARÊ







HÁ 12 ANOS OFERECE DIVERSIDADE EM FLORES E DECORAÇÃO RAINHA DA FACILPA ESTÁ CHEGANDO! INSCRIÇÕES ABREM NO PRÓXIMO DIA 13
TOXINA BOTULÍNICA
DR. JOÃO LUÍS GIL JORGE FALA SOBRE MITOS E VERDADES
















OCarnaval de Alegria será realizado entre os dias 18 e 21 de fevereiro em Lençóis Paulista, mas a folia já começa neste domingo (12), com o Projeto Samba Verão, Pré-Carnaval e show da Banda Chega na Vibe, às 15h, no anfiteatro do Parque do Povo. Além dos shows musicais com apresentações ao vivo, matinês, oficinas de máscaras e o tradicional banho de espuma, o carnaval lençoense terá desfile de blocos pela rua 15 de Novembro.
Para as apresentações de blocos, que abrem o Carnaval no dia 18, serão distribuídos abadás aos foliões, que podem ser trocados pela doação de dois isotônicos ou dois litros de leite integral Longa Vida, ou um pacote de fraldas geriátricas. A data para retirada do adereço será definida pela Secretaria de Cultura.
A Prefeitura abriu chamamento público para a exploração de espaços públicos, visando a comercialização de alimentos e bebidas, durante a programação do Carnaval da Alegria. Mais
informações pelo site http://www2.lencoispaulista. sp.gov.br/v2/licitacoes/solicitacao/10/chamamentopublico/

“A Secretaria de Cultura vai disponibilizar toda estrutura para que os lençoenses assistam aos shows e participem de todas as atrações com toda segurança e conforto”, afirmou o secretário de Cultura, Marcelo Maganha.

Domingo (12) - 15h - Projeto Samba Verão, pré-Carnaval e show da Banda Chega na Vibe, no Anfiteatro Parque do Povo.
Sábado (18) - 9h - Concentração para Desfile de Blocos na Praça do Soldado Constitucionalista
- 10h - Desfile de Blocos : Pela Contramão, Vai Kem Ké, Unidos do Júlio Ferrari, Aranhas Negras11h30 - Chegada dos blocos no Parque do Paradão, Projeto Samba Verão com Banda Via Rádio.

Sábado (18) - 17h - Agita Lençóis com professor Marcelo Estrella - 20h
- DJ Morcego - 21h – Show Banda Vixxe na Concha Acústica.
Domingo (19) - 15h - DJ Morcego - 15h Oficina de Máscaras - 16h - Banho de Espuma - 17hAgita Lençóis com professor Marcelo Estrella - 20h - DJ Morcego - 21h
– Show Grupo MGR na Concha Acústica.
Segunda (20) - 17h - Agita Lençóis com professor Marcelo Estrella - 20h
- DJ Morcego - 21h – Show Banda Os Quatro na Concha Acústica.
Terça (21) - 15h - DJ Morcego - 15h
- Projeto Criança Feliz - 16h - Banho de Espuma - 16h – Apresentação do palhaço Faísca - 17h - Agita Lençóis com professor Marcelo Estrella - 20hDJ Morcego - 21h – Show Grupo Zero 14 na Concha Acústica.
DIRETORA
Regina MelloDEPARTAMENTO COMERCIAL

 Regina Mello // Taísa Mello
Regina Mello // Taísa Mello
JORNALISTA RESPONSÁVEL
Tânia Morbi [MTB 52.193/SP]
DIAGRAMAÇÃO E ARTE-FINAL
Cristiano Fonseca
FOTOGRAFIA Cíntia Fotografias
TIRAGEM 5 mil unidades
CIRCULAÇÃO Lençóis Paulista e Macatuba
facebook facebook.com/revistaocomercio
instagram instagram.com/revistaocomercio
youtube youtube.com/revistaocomerciooficial
twitter twitter.com/revocomercio
Fevereiro chega e com ele a alegria de podermos comemorar o Carnaval, depois dos tempos de reclusão e incertezas. As cores e a música de uma das festas mais populares do Brasil estão em todos os lugares. Agora, é festejar com sabedoria e segurança.
Em Lençóis Paulista, a prefeitura programou bailes e matinês abertas ao público, oferecendo diversão a crianças e adultos, mas os bailes particulares e privados prometem também encher a cidade de alegria.
Por falar em alegria, um dos colunistas da Revista O Comércio, o ortopedista e traumatologista, Bruno de Faria Batista, comenta sobre os benefícios da prática do beach tennis para o corpo e a mente.
sobre como é realizar o sonho de ser uma princesa de verdade.
Outra expressão de alegria, o jovem idoso Atílio Antônio dos Santos, de 89 anos, contou nesta edição o que faz para se manter forte e saudável, e assim acumular medalhas e homenagens por suas participações em
eventos de caminhada para pessoas da sua idade. Assim como o jovem Cauã Fonseca Cardozo, de 19 anos, revela com alegria a certeza de que quer continuar sendo acordeonista, profissão que escolheu e já pratica desde a infância, e que o tem levado aos palcos do Brasil.
Os
A REVISTA O COMÉRCIO é uma publicação

CNPJ: 41.465.146/0001-90 • CNPJ: 41.410.304/0001-04
E alegres também são as opções de maquiagem para o Carnaval apresentadas pela colunista Fernanda Moya. Mas, ainda mais alegres vão estar as candidatas que participarem do concurso Rainha da Facilpa, que abre suas inscrições no próximo dia 13 de fevereiro. Para falar sobre essa experiência incrível, a revista conversou com a Princesa da Facilpa de 2019. Ela fala
A revista apresenta ainda matérias importantes de esclarecimento sobre saúde mental e autoconhecimento, além de apresentar os novos serviços oferecidos na cidade que reúnem alta tecnologia para contribuir com a saúde do lençoense. Entre outras matérias.
Informação de qualidade, compartilhada de maneira séria e comprometida é o jeito da equipe da Revista O Comércio desejar a todos muita alegria neste Carnaval. E boa leitura!
Rua Padre Anchieta, nº 194 // Vila Antonieta I // Lençóis Paulista // CEP: 18.682-560 // (14) 99709-2380 // falecom@revistaocomercio.com.br // revistaocomercio.com.br. artigos assinados são de responsabilidade de seus autores, portanto, podem corresponder (ou não) à opinião desta revista. Data desta publicação: 11.fev.23.



lançamento de um selo comemorativo que será usado em todas as comunicações da Acilpa durante o ano. “O desenvolvimento de um selo serve para marcar todas as ações que serão realizadas em comemoração aos 50 anos da Acilpa ao longo de 2023”, afirma o presidente.
Nas próximas semanas a direção da Acilpa vai divulgar uma série de ações que serão realizadas, além do calendário tradicional de eventos que a instituição realiza. “Vamos seguir com as ações na Rua Quinze de Novembro, com as campanhas sazonais, com nosso braço social e com o Jantar dos Empresários”, garante Toni.


Oano de 2023 é especial para o comércio e a indústria lençoenses. Esse ano, no dia 17 de outubro, a Associação Comercial e Industrial de Lençóis Paulista (Acilpa) comemora 50 anos de fundação. “Fico honrado em estar presidente da

Associação Comercial no ano em que a instituição comemora 5 décadas de trabalho pelo empreendedorismo lençoense”, comemora Toni Anderson Diegoli, presidente da Acilpa. “Ao longo desses anos, a Associação fez muito por Lençóis
Paulista, desde a área do desenvolvimento, que está mais próximo do objetivo de uma Associação Comercial, passando pela segurança pública, social, chegando até a área cultural”, destaca Toni.



A primeira ação da entidade classista é o
Além dos projetos de comunicação que serão desenvolvidos, um dos eventos que promete marcar os 50 anos da Acilpa é o esperado Jantar dos Empresários. “Este ano, o nosso jantar será especial. Criamos uma comissão para a festa e já iniciamos os preparativos do evento, ainda em 2022. Tudo para surpreender de maneira positiva nossos associados e marcar o Jantar dos Empresários de 2023 como o melhor da história da Acilpa”, conclui Toni.


Cumprindo seu sexto mandato e à frente do comando da Câmara de Lençóis Paulista pela terceira vez, o vereador Nardeli da Silva deve alcançar o marco histórico de ser o parlamentar que mais presidiu o Legislativo lençoense, ao completar sua gestão em 2024, quando ocorrerão as eleições municipais, para ele, uma possibilidade de ingressar no Executivo. Sobre a administração da Câmara, Nardeli revelou que é preciso ter cuidado , já que todas

as decisões são fiscalizadas pelo Tribunal de Contas, que pode reprovar as contas do gestor e até impedir uma futura eleição. “As pessoas pensam que a dificuldade é no plenário, mas lá uma posição nossa pode ser questionada por outro vereador. Aqui lidamos, inclusive, com os funcionários. Então, é preciso cuidado”, afirmou.
A Câmara está em processo de contratação de uma empresa que realizará concurso público, depois de muitos anos sem a contratação de servidores de carreira. Embora o processo tenha sido iniciado pelo ex-presidente, Jucimário Cerqueira dos Santos, será concluído por Nardeli. “Temos deficiência destes profissionais que sejam concursados para prestar esses serviços”, apontou.
Separando a gestão da Câmara das relações políticas, Nardeli não nega que pode concorrer em 2024 ao Executivo, seja como prefeito ou vice, desde que haja uma aliança do grupo político e a indicação do prefeito Anderson Prado.
Embora alguns nomes já despontem como possíveis sucessores a Prado, como o presidente do SAAE, André Sasso, e do próprio vice-prefeito, Manoel dos Santos Silva, a definição ocorrerá, na opinião de Nardeli, a partir do consenso. “Nosso grupo é pequeno, mas nós garantimos à população que o Prado faria um bom governo. Por isso, temos uma responsabilidade muito grande. Mas, só quem tiver a indicação do prefeito vai prosperar”, avaliou.

Em seus mandatos anteriores, Nardeli sempre assumiu o papel de oposição, o que hoje não ocorre. Embora admita ter saudade dos grandes embates políticos, avalia que a função de opositor atual é diferente. “O importante é ser questionador. Sou fiador do governo do Prado e quando questiono é direto com ele. Só temos que ajudá-lo a governar e cuidar para que não erre, o que é feito nos bastidores”, esclareceu.
Nardeli ressalta a importância de o eleitor estar mais politizado e informado, mas lamenta que as informações do mundo político cheguem de forma distorcida, levando as pessoas a formarem opiniões que não condizem com a verdade. “Seria importante as pessoas procurarem informações em fontes confiáveis. Temos sites e canais de comunicação que são oficiais, onde não se pode divulgar inverdades, porque são fiscalizados pela Justiça. As fake news impedem que as pessoas se politizem de maneira saudável. As pessoas precisam saber em quem acreditar”, alertou.

Quando Vander José Jacom Júnior e Lucilene Aparecida Gama Jacom assumiram a gestão do escritório Jacom Inteligência Contábil decidiram oferecer um novo estilo de trabalho, mais moderno e humanizado. Deu certo e o escritório hoje é referência do setor, atendendo clientes em todo Brasil e no exterior.
Deixar o mundo corporativo, após construir uma carreira de sucesso, foi
um desafio para Vander, mas gerenciar o negócio edificado pelo pai se mostrou ser a decisão correta, ao lado de Lucilene.
Tanto que na pandemia, a carteira de clientes do escritório cresceu exponencialmente, como reflexo do estilo de trabalho implantado. “Nosso diferencial é o atendimento mais próximo, personalizado, explicativo, onde o empresário tem todas as informações sobre a empresa e para o que realmente serve o escritório de contabilidade. Não é só um gasto necessário. Estamos juntos, contribuindo na tomada de decisão, orientando nos setores financeiro e tributário, e explicando como funciona cada um”, afirmou Lucilene.

As mudanças que impactam a vida
da empresa são constantes, por isso, é importante, na sua avaliação, que o empresário esteja informado do que acontece, para que possa escolher as opções que resultem em ganhos reais.
Isso, sem importar o tamanho do negócio, pois no Jacom Inteligência Contábil todos são atendidos de forma diferenciada. A equipe acredita que um serviço personalizado pode ser acessível a qualquer empresa. “Nosso suporte é de acordo com a necessidade do empresário. Com uma boa análise, conseguimos um bom relacionamento e oferecer bom atendimento com o mesmo preço praticado no mercado”.



O resultado, afirma Lucilene, são vários cases de sucesso entre MEIs atendidos, o que
rendeu uma matéria jornalística da TV Tem. “Vários empresários que começaram aqui como MEI, hoje cresceram e estão bem”, comemora. A humanização nas relações está impregnada na forma como Lucilene e Vander administram seu negócio. Com a implantação da Contabilidade Consultiva, o escritório se coloca como parceiro do empresário. “Nossa visão e objetivo é sermos reconhecidos como melhores no mercado, vistos e reconhecidos pelo melhor atendimento, prestação de serviço e por oferecer as melhores ferramentas para o crescimento da empresa. Nós temos muitas informações e usamos estas informações para orientar o empresário sobre as melhores decisões”, explica.
Para isso, também na equipe de atendimento a informação é compartilhada, e a equipe é estimulada a crescer profissionalmente. A maior parte possui níveis Sênior e Pleno, e todos estão preparados para amparar os empresários que necessitem de informação ou orientação.




“A gente preza muito pela qualidade profissional do nosso time, pela formação e qualificação de todos. Preparamos a equipe para que tenha expertise para atender aos empresários”, garante.

Na equipe, cada um é responsável pelo seu horário de trabalho, com opção de trabalhar
home office. Às quintas-feiras, a hora do bolo é dedicada à confraternização da equipe e clientes. Além da qualificação de seus profissionais, Lucilene ressalta que o investimento em tecnologia é constante, tanto que para 2023 o objetivo é eliminar o uso de papel e ser 100% digital.




As semijoias estão cada vez mais em alta entre as mulheres que querem realçar sua beleza com peças finas, delicadas e produzidas com excelentes e diversificados materiais, sem ter que gastar muito. Especialmente, com a facilidade de ter a opção de comprar e receber suas compras na forma presencial ou online.



Isso explica o sucesso da loja Morganita Semijoias, que em três anos atingiu mais de 1.000 clientes atendidos na loja física, o que levou ao lançamento do e-commerce há 6
meses, com peças despachadas para 11 estados do Brasil. Segundo suas proprietárias Aline G. Lourenção e Silviane C. de Souza Zinhani, “despachando autoestima através de joias e semijoias para todo país”.
As peças da Morganita são de marca própria, sempre atendendo as principais tendências no mundo da moda. “Trabalhamos com joias na Prata 925 e semijoias que são banhadas a ouro 18K, no ródio branco e ródio negro. Ainda temos à pronta entrega uma infinidade de modelos de alianças no aço 316 L. Todas as peças são hipoalergênicas, com um ano de garantia. Além da linha feminina, contamos com linha exclusiva masculina, infantil, acessórios de cabelo e berloques”, apresentou Aline.
O sucesso da marca, segundo Silviane, é explicado pelo fato de que as peças Morganita são tão bonitas e elegantes quanto as joias, mas com melhores preços. “As semijoias de luxo são elaboradas com metais nobres e possuem acabamento impecável. Sempre foi uma referência para quem preza pela durabilidade das peças, mas atualmente o segmento vem diversificando cada vez mais, portanto é o casamento perfeito entre moda e luxo para que a mulher moderna possa usar
designs contemporâneos e sofisticados feitos de materiais de qualidade a um preço muito mais acessível”, explica.




Depois do sucesso da loja física, as empresárias apostaram na opção online, com uma estrutura digital adequada à demanda, que tem proporcionado atender as clientes de todo Brasil, com total segurança para quem faz seus pedidos e recebe em casa. “Desde que inauguramos a loja física, comercializamos para todo o país, porém com atendimento via WhatsApp e Instagram, mas o perfil do consumidor está cada vez mais dinâmico. Por este motivo, resolvemos ampliar nossos canais de vendas com o e-commerce e atender clientes de todo o Brasil, de maneira segura, 24 horas por dia nos 7 dias da semana”, conta Aline. São mais de 3.000 produtos disponíveis, com novidades semanais. A loja toda na palma da mão, na hora mais viável para cada cliente. Para quem é de Lençóis Paulista, têm a comodidade de realizar a compra e solicitar a retirada na loja física, sem a necessidade de pagamento do frete, já que apesar do sucesso da loja virtual, as proprietárias pretendem manter a loja física, que conta com estacionamento exclusivo. “Amamos a experiência do contato
Rua Coronel Virgílio Rocha, 228 – Centro Telefone: (14) 99825-8472


https://morganitajoias.com.br
olho no olho, o cafezinho e o bate-papo com cada cliente. Contamos com um espaço para atendimento exclusivo, que pode ser individual ou em grupo. Na loja, os maridos ou namorados, filhos e até os bichinhos de estimação são bem-vindos. Será sempre um prazer atender a todos!”, garante Silviane.

SITE DO CONCURSO RAINHA DA FACILPA SERÁ CRIADO E MANTIDO POR
AGálata desenvolve soluções para pequenas, médias e grandes empresas, através do uso de ferramentas e tecnologias de ponta. Seu objetivo é customizar projetos, de acordo com a necessidade de seus clientes, oferecendo plataformas profissionais em ambientes online (SaaS), com excelente custo benefício para os empreendedores e donos de pequenos negócios, mas que querem


estar presentes no universo digital. Isso é possível por meio da extensa trajetória de seus sócios no mercado digital e de tecnologia, que somam mais de 20 anos de experiência cada.
Atualmente, atua em 3 principais frentes de negócios: a Gálata Tecnologia, onde são desenvolvidos projetos personalizados para ambientes online (SaaS) e baseados nos objetivos de negócios do cliente, utilizando a expertise de sua equipe em oferecer uma solução eficaz e assertiva.
Ainda com a plataforma de criação de sites pela qual seus clientes podem trabalhar pelo formato “faça você mesmo” ou contar com a criação de sua equipe baseada nas

necessidades apontadas. É esta ferramenta que irá atender ao site da Rainha da Facilpa, promovido pela Revista O Comércio, por ser uma estrutura robusta e estável.
E finalmente, a plataforma de catálogo online para receber pedidos no WhatsApp que oferece praticidade, agilidade e experiência para quem vende online pelo aplicativo. Na plataforma do Categorize o cliente pode ter uma página exclusiva e desenvolvida para facilitar a navegação e pesquisa dos seus produtos e serviços. Entre os mais de 300 clientes da empresa, que estão em mais de 70 cidades, distribuídos em 15 estados e mais de 5 países, na região de Lençóis estão a rede Confiança Supermercados, Concilig, HCosta, Gera Arte, Apae Bauru, Rede do Câncer de Lençóis, LSC Contabilidade, entre outros. Todos contam com as soluções tecnológicas da Gálata, de acordo com suas necessidades. Isso, porque a empresa oferece plataformas armazenadas em nuvem para acesso online, onde é possível oferecer e entregar as ferramentas e estruturas mais avançadas a um custo acessível para qualquer empresa, onde os clientes podem



utilizar da maneira que fizer mais sentido para cada negócio, sejam empresas de pequeno, médio e grande porte, ou pessoas que buscam presença digital.
A experiência da Gálata confirma que a transformação digital é um processo comum que precisa ser seguido pelas empresas que querem se manter e destacar no mercado. A Inteligência Artificial tem evoluído cada vez mais e a presença digital é uma condição e não mais uma opção.


Ainda existem muitas empresas que não estão nesse processo, mas que com as necessidades do ambiente tecnológico dos dias atuais, não terão como fugir. E são essas empresas que a Gálata está pronta e disposta para oferecer soluções práticas, que funcionem para cada negócio. Para isso, conta com uma equipe de 16 profissionais, com a perspectiva de finalizar 2023 com um time que pode dobrar de tamanho.
serviço:
www.galata.com.br
| Telefone: (14) 4141-0454 contato@galata.com.br



de Abreu, conhecida carinhosamente como Lala, surgiu de uma homenagem feita por seu filho, David Emiliano Abreu Gonzalez, mas depois de tanto tempo de sucesso, se tornou comum para toda a cidade.
Lala conta que, quando abriram a loja, seu filho David já tinha o nome em mente, formado pelas iniciais, segundo ele, das três ‘mulheres mais importantes da sua vida’: Janaína, a esposa; Lala, a mãe, e Rebeca, a filha.
Gouveia
Há 12 anos a Janlarê surgiu como um espaço para oferecer todos os materiais usados por quem pratica jardinagem ou gosta de trabalhar com flores artificiais. Mas, com o passar do tempo, a loja foi crescendo e hoje conta com uma diversidade de presentes, peças para casa e decoração. O nome, segundo contou Maria Eulália
De lá para cá, a loja se tornou referência em produtos de jardinagem. Começando com os materiais básicos e mais importantes, especialmente, vasos, terra, pedras, argila, cascas, musgos e outros. “Depois fomos acrescentando

brinquedos, peças de decoração, e hoje contamos com móveis em MDF, produtos eletrônicos e muitas peças de decoração”, explicou Lala.

A loja, que é vizinha do Magazine Dinossauro, também de propriedade da família, foi a opção para oferecer produtos pelos quais Lala é apaixonada, e que a primeira loja não tinha condições de oferecer, por já contar com uma oferta muito variada.

Além da diversidade, as duas lojas também reforçam os produtos típicos de datas comemorativas ao longo do ano, como Dia das Mães, Dias dos Namorados, Dia dos Pais, Páscoa e Natal.
Na Janlarê, o momento especial será a Páscoa e a loja já está sendo preparada para oferecer tudo o que é necessário para quem fabrica ovos de chocolate ou monta cestas de presentes e outros produtos típicos.

Já na Dinossauros, a preparação é para o Carnaval que está chegando. Quem quiser decorar a casa, criar uma fantasia ou mesmo se enfeitar para a festa encontra muito material na loja.

Contando com ajuda de Ademir e Clarice,
seus colaboradores na Janlarê, e com a equipe do Magazine, todos orientados para atender da melhor forma possível. “Eu tenho sempre a preocupação que nossos colaboradores atendam da mesma maneira que gostariam de serem atendidos. É assim que a gente orienta a todos”, explicou Lala.


Oque seria o explante mamário? É um assunto que muitos estão falando em grupos de whatsapp, mídias sociais e conversas entre amigas, etc. Inclusive, no meu canal, já abordamos um pouco desse assunto quando publiquei o vídeo sobre a doença do silicone, síndrome ASIA. Quem se interessar, corre lá e assista o vídeo. Mas o assunto hoje é explante (retirada das próteses mamárias) e principalmente como podem ficar as mamas após um explante.
Hoje a maior parte das pacientes realiza a troca dos implantes mamários por vários motivos:
- Desejo de aumento ou diminuição do volume mamário.
- Desejo de nova subida das mamas.
- Necessidade de troca devido a contratura, rompimento ou infecção das próteses, etc.
Essas pacientes se adaptaram ao silicone e desejam manter.
Uma parcela crescente de mulheres está nos procurando para a retirada do implante mamário. Existem vários motivos:
- A própria doença do silicone (incômodo, sintomas relacionados como dores, alergias, etc).
- Desejo de retirar algo que as incomodam.
- Reduzir as mamas simplesmente.
- Motivos particulares, religiosos, etc.
O desejo de manter ou retirar é exclusivamente da paciente, cabe a nós médicos, orientar e esclarecer todas a duvidas
para que vocês decidam com mais segurança. Vou focar no que vocês precisam saber sobre o aspecto da mama após a retirada do silicone. Paciente com mama pequena e moderada com implante mamário:
Nesse caso, imaginem uma paciente com histórico de uma mama pequena ou moderada com colocação de próteses mamarias há um certo tempo. E agora, deseja retirar. Nesse período que ela ficou com as próteses, a pele da mama se distendeu para acomodar o volume da prótese mamaria. Certamente, ao retirar a prótese, a pele ficará com sobras. Essa sobra vai depender do volume de prótese que eu retirar e também da pele da paciente, porém, todas a mamas provavelmente ficarão com um aspecto mais murcho.
Se após retirar a prótese, as mamas ficarem com queda, ou seja, a aréola ficar abaixo do sulco mamário, podemos fazer o que chamamos de mastopexia, ou seja, levantar a aréola ganhando aquela cicatriz em pirulito
ou raquete e podendo ter a cicatriz horizontal. Certamente a mama ficará menor.
PACIENTE COM MAMA GRANDE COM IMPLANTE MAMÁRIO: Nesse caso, se a paciente deseja a retirada das próteses e ao mesmo tempo reduzir as mamas, temos uma vantagem pois eu consigo retirar o volume das próteses, subir a aréola, caso ela tenha caído, e deixar a mama com um volume menor, mais próximo ao que a paciente deseja. No entanto, eu não consigo retirar o volume das próteses e manter a mama do mesmo tamanho.
Portanto, se vocês decidirem por retirar as suas próteses de silicone, independente dos motivos, agende uma consulta com o seu cirurgião plástico e converse com ele sobre esse aspecto e como ficarão suas mamas após a retirada. Tenho certeza que ele vai te ajudar a entender e assim, fica mais fácil você tomar a decisão.
Enfim, esta é apenas uma maneira bem resumida de explicar essas duas opções de colocação de próteses nas mamas, e certamente, muitas mulheres continuarão com muitas dúvidas após ler a matéria, porém, estou aqui para isso! Estou disponível no meu canal do Youtube (www.youtube.com/drjoaoluis), no meu Instagram e também no meu consultório no Centro médico Rosaclin.

Acreditamos que as oportunidades de vivências positivas que temos em nossas vidas são sementes plantadas em nosso coração e nossa memória. O que nos sensibiliza gera mudança. O que gera mudança, muda futuros e cria condições para transformar sonhos em histórias de verdade.
O Projeto Formação de Líderes (PFL) tem esse propósito: gerar mudanças que inspirem adolescentes e jovens a sonharem, conhecerem seus talentos e habilidades e decidirem por fazerem escolhas que os levem a caminhos de prosperidade.
Uma história de verdade é a do Michel Henrique, aluno do PFL da turma de 2022.
Antes de participar do projeto, Michel era um menino muito quieto e tinha uma insegurança que o deixava com medo de não fazer novas amizades e não conseguir entender as aulas do curso. Mesmo assim, fez sua inscrição motivado por sua prima e sua mãe. Em cada aula, sua habilidade e conhecimento o motivaram a dar o seu melhor. Com o passar do tempo, tornou-se amigo de cada aluno da turma; reflexo das atividades em grupo e individuais do curso. Os temas que o inspiraram trataram de assuntos como administração do tempo, responsabilidade, liderança e empatia.
Michel também adquiriu habilidades para falar em público, que, para ele e para a maioria dos adolescentes e jovens, é uma das maiores dificuldades. E assim, durante dez meses, cada aula do PFL que fazia tocava seu coração de forma diferente. No dia da formatura, Michel se deu conta de sua conquista: terminou o curso.
E, junto com todos os seus amigos e seus familiares, percebeu que é em um ambiente em que existe respeito, empatia e troca de conhecimento que pode ser descoberto o sentido para a vida de um jovem, assim como aconteceu com ele, o Michel, na foto ao lado com Carla Branco, superintendente do Instituto LideraJovem no dia da formatura.
Há mais de 20 anos, histórias como essas são realidade entre os adolescentes e jovens que participam do Projeto Formação de Líderes (PFL), realizado pelo Instituto LideraJovem, uma Organização Social Civil (OSC) sediada em Lençóis Paulista.
Para viver essa experiência também, basta
preencher o formulário de inscrição que está no site www.liderajovem.org até o dia 19 de fevereiro. Em março, acontecerá a etapa de seleção composta por dinâmicas e atividades que, por si só, promovem uma experiência positiva aos participantes. Serão duas turmas com 35 vagas cada, uma na parte da manhã e outra à tarde. As aulas acontecem durante 10 meses na sede do Instituto LideraJovem, no centro de Lençóis Paulista.

Conheça mais sobre o Instituto LideraJovem pelo site liderajovem.org, os perfis do Facebook e Instagram @institutoliderajovem, o canal do YouTube ou entrar em contato pelo telefone (14) 9.9735-1240.


Qual jovem ou adolescente nunca sonhou em ser uma Princesa? A Revista O Comércio proporciona que este sonho se realize e a chance de o tornar real está chegando. Qualquer garota que se inscrever no concurso Rainha da Facilpa 2023, e assim como aconteceu com Flaviane Reis, em 2019, poderá estar entre as escolhidas e fazer parte da realeza, durante os dias de feira, e entrar para a história deste importante evento, organizado pela Revista O Comércio em parceria com a Associação Rural e Prefeitura de Lençóis Paulista.
As inscrições, aliás, vão estar abertas a partir deste dia
13 de fevereiro e vão até o dia 3 de março, apenas pelo site www.rainhadafacilpaoficial.com.br.


Prestes a iniciar as inscrições, Flaviane comentou como foi para ela realizar o sonho de ser Princesa da Facilpa. Veja o recado que ela deu a todas que estão pensando em se inscrever. “Que se entreguem de corpo e alma”.
O COMÉRCIO: POR QUE VOCÊ DECIDIU PARTICIPAR DO RAINHA DA FACILPA?
FLAVIANE REIS: Porque um dos meus sonhos era representar Lençóis Paulista, fazer parte dessa história! Eu sempre admirei o concurso, desde quando iniciou. Acompanhava todos os anos e sentia a emoção ao ver as finalistas e principalmente em cada corte que se formava.
O COMÉRCIO: COMO FOI PARA VOCÊ PARTICIPAR?
FLAVIANE REIS: Tudo começou em 2016, quando participei pela primeira vez. Cheguei entre as finalistas, porém, não entrei na corte. A mesma coisa aconteceu em 2017. Participei, entrei como finalista, mas não foi daquela vez! Em 2018, eu não participei, pois estava em uma nova fase na minha vida profissional. O meu ano foi 2019. Meu coração gritava “Vaaaai” rsrs.
O COMÉRCIO: COMO FOI FICAR ENTRE AS FINALISTAS E SER PRINCESA DO CONCURSO?
FLAVIANE REIS: A sensação de chegar entre as finalistas foi sentir que o meu sonho estava muito próximo e possível de se realizar! E não é que chegou? A hora que anunciaram a minha pontuação (726 pontos) e logo em seguida o meu nome como Princesa da Facilpa 2019, só ouvi e senti Deus falando em meu ouvido “Essa é sua”.
O COMÉRCIO: VOCÊ TINHA ALGUM SONHO DE SEGUIR NESSE RAMO DA BELEZA?
FLAVIANE REIS: De certa forma sim! Pois adoro tirar fotos e gravar vídeos, principalmente para lojas de roupas.

O COMÉRCIO: O QUE DIRIA PARA AS MENINAS QUE

PENSAM EM PARTICIPAR?

FLAVIANE REIS: Eu digo que se entreguem de corpo e alma! O medo sempre vai existir em nossas vidas, eu também senti! Porém, a minha vontade e o meu sonho eram maiores que o meu medo, sendo assim, o meu sonho superou todos e quaisquer tipos de receios. Meninas, não percam essa oportunidade! Para você que gostaria de representar Lençóis Paulista como Rainha ou fazendo parte da corte, só vai! Se entregue! Você não vai se arrepender! Pelo contrário, quando acaba, da vontade de passar por tudo novamente, eu mesma passaria.
O COMÉRCIO: O QUE DIRIA DA ORGANIZAÇÃO DO EVENTO?
FLAVIANE REIS: Quanto à organização do evento, sempre foram muito atenciosos desde a minha primeira participação! Me senti super à vontade e acolhida.
O COMÉRCIO: E DA SERIEDADE DA COMPETIÇÃO, DIRIA QUE O CONCURSO REFLETE REALMENTE A VOTAÇÃO POPULAR?
FLAVIANE REIS: Com certeza! Inclusive, eu junto com a Rainha e a madrinha, tivemos a oportunidade de ver nossas quantidades de votos alguns dias após a eleição na Revista O Comércio. Sentimos o incentivo da população muito forte conosco.
mundo, durante o Campeonato Mundial de Acordeonistas, realizado na China, onde venceu na categoria Virtuoso Sênior.
Mas, começar a tocar foi mesmo por curiosidade, revela Cauã. “Comecei a tocar por uma vontade mesmo, foi espontâneo, por ter curiosidade sobre o instrumento”, diz.
Por conta do seu trabalho como músico, ele toca a maior parte do tempo composições do estilo sertanejo, mas ouve todos os estilos. “Ouço e procuro conhecer um pouco de todos os estilos possíveis”, revela.
Cauã Fonseca Cardozo tem apenas 19 anos, mas a determinação e a certeza do que quer como sua profissão. E olha que a escolha foge do padrão dos jovens da sua idade, já que ele é acordeonista
e já possui experiência para percorrer palcos pelo Brasil, se apresentando profissionalmente.
Ele conta que aprendeu a tocar acordeon há cerca de 10 anos, ou seja,

quando ainda era uma criança. A paixão pela música e pelo instrumento foi direcionada pelas aulas com Gustavo Almeida, catarinense de 22 anos que, em 2019, foi eleito o melhor acordeonista do
Atualmente, Cauã acompanha a dupla Hugo e Tiago, que vem se destacando no cenário, com shows por todo país. Seu ídolo é um dos melhores acordeonistas do país, o gaúcho Renato Borghetti.

Para o futuro, o jovem músico espera poder continuar investindo em experiência e aprendizado e assim continuar se mantendo por meio do que mais gosta de fazer que é tocar acordeon. “Pretendo continuar nessa carreira”, projeta.

Em agosto de 2022 o México voltou a exigir visto impresso para entrada de brasileiros. Ou seja, uma preocupação a mais para quem viajar para Cancun e outros lugares de tirar o fôlego na costa caribenha do país.
Embora Cancun sempre seja uma boa ideia, a boa notícia é que há muitos destinos para curtir o Caribe sem visto. A maioria dos países banhados pelo Mar do Caribe, aliás, não exige o documento para brasileiros.



Sendo assim, a República Dominicana é uma excelente opção, e hoje entre os destinos caribenhos mais procurados pelos brasileiros. De modo geral, Punta Cana é um hit caribenho entre brasileiros. A fórmula ali é simples: praias lindas com mar azul fluorescente e mais de oitenta resorts enfileirados um atrás do outro com piscina, spa, atividades e alimentação e bebidas à vontade. Além de passeios que te levarão a ilhotas paradisíacas próximas, como Isla Saona.
E este foi o último destino que a equipe Viagem & Cia foi visitar. E quem foi conferir tudo de pertinho, foi a consultora Isadora Capoani, que foi presenteada com águas translucidas e mornas, areia clarinha e coqueiros verdes. Ou seja: do jeito que quase todo mundo imagina um lugar paradisíaco. Ou seja, um verdadeiro destino ‘instagramável’.
Um dos pontos fortes da região é o fato de saber combinar diversão e sossego, infraestrutura e muito pé na areia, desdobrando-se para superar as expectativas de quem desembarca por ali, conta Isadora. O destino possui ampla oferta de passeios, uma grande variedade e diferentes categorias de hotéis e resorts, os quais Isadora pode conhecer de pertinho.


E dentre as principais experiências que Punta Cana oferece estão o nado com golfinhos, conhecer o cenote Hoyo Azul, visitar a Playa Bávara, pegar uma onda na Playa Macao, que é considerada uma das mais bonitas do país, ou curtir a atmosfera de paz e beleza cenográfica da Playa Juanillo, cujo acesso é controlado.
O Caribe sempre surpreende!

Site cintiafotografias.com.br Facebook @cintiafotografiaslp Instagram @cintiafotografias













O QUE É CONSTRUÇÃO MODULAR?
Poderíamos considerar a Construção Modular (CM) como uma metodologia de construção, em que partes ou seções repetidas de uma edifi cação (módulos), são produzidas em uma fábrica (offsite), conforme processos e condições controlados. Os módulos são transportados e montados no local da obra (on-site) e podem ser dispostos lado a lado ou empilhados, permitindo uma variedade de configurações e de estilos. Após a montagem, os módulos são conectados para formar a edificação.
A Construção Modular substitui a construção tradicional com vantagens significativas, garantindo previsibilidade de entrega, melhor qualidade e desempenho e produtos mais sustentáveis. Com a Construção Modular, é possível a redução de até 50% dos prazos e de até 20% dos custos das edificações produzidas.

Estes percentuais são modestos, se considerarmos a exploração das ferramentas de Pré-construção e de
Fast Construction para a racionalização e ganho de eficácia dos processos. Contudo, como em qualquer tipo de industrialização, os benefícios gerados pela CM dependem de ganho de escala. Mas é uma tendência muito forte, sem volta e questão de sobrevivência no mercado da construção civil.
Nos últimos 10 anos, este tipo de construção tem registrado um crescimento significativo no mundo –dobrou de tamanho nos últimos 5 anos – mostrando que veio para ficar.
Seus métodos são subdivididos em painéis 2D e módulos 3D. Os sistemas 2D são mais frequentemente usados. Incluem-se nesta categoria os painéis planos e completos de fechamento interno (paredes) e externo (painéis de fachada) e ainda, os painéis de cobertura e de piso.
Como exemplo de uso temporário, estão escolas, hospitais, habitações provisórias civis e militares, além de vestiários e banheiros para uso em eventos e canteiros de obras.
Para composição dos módulos 3D são utilizados painéis 2D, por exemplo, nos fechamentos internos (paredes) e externos (fachadas), bem como nos painéis de cobertura e de piso. No
caso da CM volumétrica, praticamente todos os acabamentos internos e boa parte dos externos chegam concluídos no local da obra.
Como consequência, os prazos de montagem são mais curtos e há maior segurança para os profissionais envolvidos.
Apesar das vantagens do emprego da CM, a partir de módulos 3D, por
uma questão de fl exibilidade, logística e transporte muitas vezes é mais racional o uso de um sistema híbrido.
Quer conhecer mais o sistema? Quer ter uma casa, comércio, indústria no sistema modular? Contate ATS Construções Inteligentes e fale com o diretor executivo, engenheiro Alessandro Sene.


Apesar dos 25 anos de experiência, a odontologista Eve Temer Feres, especialista em endodontia, continua buscando o aperfeiçoamento e atualização em uma das profissões que mais se transformou nos últimos anos, com o surgimento de técnicas e recursos que tornaram o tratamento odontológico muito mais diversificado e acessível.
Ela compara a época em que se formou na faculdade e a atual para garantir que a profissão mudou muito. “Antes eram poucos dentistas que, de maneira geral, ofereciam pouca diferença no atendimento. Hoje, felizmente, o número é bem maior de profissionais e temos que nos adequar ao que o consultório exige. Se aparece na clínica, por exemplo, a procura por uma especialidade, porque não estudar e ampliar meu conhecimento?”, comenta.
Uma das áreas que ela sempre atuou e que também hoje é
muito mais conhecida e procurada pelos pacientes, a estética tem sido destaque na oferta de serviços odontológicos, especialmente, a implantação de resina que surgiu como opção à porcelana, que apesar de muitos benefícios, tem uso mais oneroso. “No começo, a porcelana era mais procurada por seus benefícios, mas é um procedimento mais custoso. A resina é bem mais acessível e tão boa quanto, desde que o material usado tenha boa qualidade e a aplicação seja correta”, diz.
Para oferecer o atendimento com alta qualidade, Eve se dedica a se manter atualizada, com cursos e atualizações. No final de janeiro participou do Congresso Internacional de Odontologia de São Paulo (CIOSP), que em sua 40ª edição apresentou inovações do mercado odontológico e aperfeiçoamento profissional.
Mas, não foi apenas no setor de estética que a profissão se transformou. Eve vê a mudança na profissão como positiva, não apenas por popularizar os procedimentos, proporcionando que mais pessoas cuidem da saúde bucal, mas também por determinar que os profissionais busquem mais qualificação e diversidade em seus conhecimentos. “Nós somos mais exigidos, porque os clientes têm mais acesso a informações. Ao mesmo tempo, contamos com materiais e técnicas mais modernos, por isso, temos condição de oferecer muito mais a nossos pacientes. Então, nossa profissão melhorou muito”, avalia.
O cuidado com a qualidade do atendimento também levou a dentista a reformar por completo seu consultório para oferecer um espaço mais confortável e moderno.

PESSOAL
A profissional Eve Temer Feres é bem menos tranquila



que a esposa e mãe, já que ela confessa que a preocupação em oferecer o melhor atendimento, algumas vezes, a deixa tensa. Na vida pessoal, Eve diz que é bem mais calma, embora também admita que o fato de gostar de tudo bem organizado faz com que seja exigente, tanto no consultório como em casa.

Eve é casada com o advogado Glauco Temer Feres e tem duas filhas: Mariana, de 16 anos, e Laura, de 15 anos. De personalidade mais reservada, e apesar de ampla experiência profissional e estar no mesmo endereço há

15 anos, percebeu a necessidade de ampliar a visibilidade do seu trabalho, como forma de se adequar ao momento que exige maior exposição, por meio de redes sociais, em todas as áreas profissionais.





Obeach tennis é um esporte que traz muitos benefícios para o corpo e a mente. A modalidade vem ganhando cada vez mais adeptos no país —segundo a CBT (Confederação Brasileira de Tênis), cerca de um 1,1 milhão de pessoas praticam a atividade atualmente, mais que o dobro em comparação a 2019.
SEGUEM AO LADO ALGUNS BENEFÍCIOS DE JOGAR BEACH TENNIS:
1 - Baixo impacto nas articulações: Além de o praticante ter de saltar e correr menos do que ao jogar vôlei e futebol, por exemplo, a areia fofa reduz o impacto nos joelhos, tornozelos, quadris e costas, minimizando o risco de dores e lesões.
2 - A família toda pode jogar: Até quem está sedentário ou nunca praticou esportes com raquetes consegue jogar beach tennis. A atividade é inclusiva e na quadra vemos de criança a idosos. O esporte envolve a família e amigos.
3 - Não é preciso muitos jogadores: Muitas vezes, você nem precisa de um parceiro para jogar. Diversas arenas oferecem um tipo de “day use” em que é só chegar e jogar com quem estiver lá na quadra.
4 - Fortalece o corpo todo: Mover-se na areia, saltar e agachar para alcançar a bola ajuda no ganho de força nas pernas e na região do core (abdome, lombar e coluna). Já as raquetadas trabalham braços e ombros
5 - Detona calorias: O beach tennis é um esporte que propõe um exercício intervalado, ou seja, mescla momentos de alta e baixa intensidades. Em uma partida de 60 minutos em duplas, um atleta amador faz aproximadamente 10 minutos de atividade intensa e queima cerca de 200 calorias —mas esse número pode aumentar, dependendo do ritmo do jogo.
6 - Melhora o fôlego: Correr e saltar na quadra proporciona um trabalho aeróbico, que contribui para desenvolver o condicionamento cardiovascular (resistência física).

7 - Turbina o humor e despacha o estresse: Assim como qualquer atividade física, o esporte estimula a produção de neurotransmissores (como a endorfina) que melhoram o humor, ajudam a relaxar e aumentam o bem-estar.

8 - Desenvolve a propriocepção: A instabilidade da areia fofa estimula a capacidade do corpo em reconhecer sua posição no espaço, chamada de propriocepção —é graças a essa
capacidade que você consegue levantar as mãos na altura dos ombros sem precisar olhar para elas. Desenvolver a propriocepção ajuda na estabilização das articulações e reduz o risco de algumas lesões, como torções —ao pisar em buraco, por exemplo, seu corpo percebe que o pé está virando e aciona rapidamente os músculos necessários para evitar isso.
9 - Trabalha a coordenação motora e o equilíbrio: O esporte estimula ainda regiões cerebrais responsáveis por diferentes capacidades coordenativas, possibilitando um incremento de sinapses entre as áreas do cérebro e os músculos. Estudos mostram que esses processos podem neutralizar ou retardar o desenvolvimento e a progressão de demências, como Alzheimer.

10 - Deixa o cérebro mais esperto: Os deslocamentos na quadra contribuem para desenvolver a capacidade de processamento de informação e de reação, por exigirem tomadas de decisão rápidas para realizar uma jogada.
11 - É fácil de praticar: Apesar de as regras do beach tennis terem certa semelhança com as do tênis de quadra, o jogo na areia é mais dinâmico, simples e ágil.

alimentos contaminados por esta bactéria tinham paralisia muscular. A indústria viu o benefício da paralisia, optou por usar ela em benesses, como a parte da beleza, e para tratar espasmos de pacientes que tenham déficit neurológico. Então, ela nasceu de uma doença e foi usada para fins estéticos e de certo modo, medicamentoso”, relatou.
O COMÉRCIO: PARA QUE SERVE? SERVE APENAS PARA RUGAS?
Muitos já ouviram falar em toxina botulínica ou botox. Mas, o que realmente é e quais todas as suas destinações. Quem abordou este assunto especialmente para a Revista O Comércio foi o cirurgião plástico João Luís Gil Jorge. “A história é muito interessante, porque ela nasceu de uma toxina produzida por uma bactéria que causa paralisia. Geralmente, pessoas que consumiam
DR. JOÃO LUÍS: A toxina é conhecida pela maioria das pessoas como sendo usada para estética, mas ela nasceu para tratar paralisia muscular. Pacientes que têm déficit neurológico, espasmos, ficam em uma condição que o músculo contrai e não relaxa, então com a toxina eles têm menos dor. Também para paralisia de pregas vocais, onde o músculo também fica paralisado, ainda para tratar excesso de sudorese,
quando a paciente produz muito suor nas axilas. Ou seja, a função da toxina é imensa, e também tem para o tratamento estético, quando se paralisa a musculatura da face diminuindo as rugas que se formam com a contração voluntária.
O COMÉRCIO: QUAIS OS EFEITOS? SÃO PERMANENTES?
DR. JOÃO LUÍS: Como a maioria das substâncias que é injetada no corpo, tem período em que o corpo vai absorver ou eliminar, porque ela não é um produto original do nosso organismo. O nosso corpo leva um tempo, que segundo a literatura é de 4 a 6 meses para eliminar, mas varia de pessoa para pessoa. Quem faz mais exercícios, quebra essa toxina mais rapidamente, em pessoas que têm dificuldade em metabolizar, dura um pouco mais. E são poucas as que não tem reação, não conseguem paralisar.


O COMÉRCIO: QUEM PODE USAR? COM QUAL IDADE?
DR. JOÃO LUÍS: Ela vem sendo usada cada vez mais precocemente, como uma profilaxia, ou seja, para evitar com que a pessoa forme rugas desde jovens. Já vi pessoas usar com 17 ou 18 anos, mas a gente orienta o uso a partir dos 18 anos. Antes era usado apenas depois que se formou a ruga, hoje não. É usado para evitar. É contraindicado em crianças e jovens com função estética, no entanto, a parte funcional é permitida, assim que tem indicação clara do médico para algum tipo de doença.
O COMÉRCIO: QUANDO É O MELHOR MOMENTO PARA USAR?
DR. JOÃO LUÍS: O melhor momento é quando a pessoa tem o conhecimento que é um tratamento, pode ser a partir dos 18 anos, ou quando tem necessidade de tratamento.
Para quem tem 30 ou 40 anos pode ser há cada 6 meses, mas a decisão é muito de cada pessoa.
O COMÉRCIO: EXISTEM MITOS EM TORNO DELA?
QUAIS OS PRINCIPAIS?
DR. JOÃO LUÍS: São vários. Antigamente falava-se que só poderia usar a partir dos 40 anos, é um mito. Que só pode usar uma vez, é mito. Que a toxina é coisa que não pode ser usada com outros produtos. Mas, pode. Um mito grande é que não se pode fazer exercício após a aplicação. Você pode fazer. A gente não recomenda não fazer exercício porque isso pode fazer mal para sua saúde. Mitos relacionados à durabilidade e uso de medicamentos. Por enquanto, não temos evidências. Existem alguns preparos à base de Fitase e Zinco, que podem diminuir a metabolização.

serviço:
Centro Médico Rosa Clin
Av. 9 de Julho, 972 - Centro - Lençóis Paulista - SP
Telefone: (14) 99785-4884


LABORATÓRIO DE ANÁLISES CLÍNICAS FOI PENSADO PARA OFERECER SERVIÇOS HUMANIZADOS E

que tivesse um perfil de trabalho, que condissesse com nossos ideais. Somos um laboratório de análises clínicas focado em resultados de alto padrão, com parceiros como as duas das maiores empresas do ramo de diagnósticos do país, Grupo Fleury e Hermes Pardini. Lançamos a marca Labstar com propósito de inovação e qualidade, visando novos conceitos na área da saúde.

Há três meses Lençóis Paulista e região contam com o laboratório Labstar, um serviço de análises clínicas altamente especializado, que dispõe das ferramentas tecnológicas mais modernas do setor, oferecidas em um ambiente confortável e aconchegante, pensado para oferecer a

melhor experiência quando o assunto é cuidar da saúde. Na entrevista desta edição da Revista O Comércio é possível conhecer um pouco mais sobre este novo serviço.
O COMÉRCIO: COMO SURGIU A IDEIA DO LABSTAR?
LABSTAR: Decidimos fundar uma empresa
O COMÉRCIO: QUAIS SERVIÇOS SÃO OFERECIDOS PELO LABORATÓRIO?
LABSTAR: Somos um laboratório 5 estrelas, por isso oferecemos vários serviços diferenciados. Pelo atendimento personalizado, o paciente faz seu agendamento direto no site ou via WhatsApp, assim, ele irá no laboratório apenas para fazer a coleta, sem filas, burocracias, com
um café exclusivo, conforme sua preferência. Realizamos mais de 40 exames com tempo de 60 minutos, contando com a parceria de um médico clínico geral, que esclarece todas as dúvidas sobre exames. Somos treinados em coletas para pacientes autistas e temos um Espaço Gestar, uma sala exclusiva para gestantes, que oferece massageador para os pés, televisão, Alexa, Kindle com vários livros sobre gestação e maternidade, ar condicionado. Neste espaço, as gestantes que precisam realizar o exame chamado curva glicêmica, que exige que ela permaneça três horas no laboratório, terá todo conforto. Ainda temos a coleta domiciliar, nas empresas e consultórios médicos. Nossos colaboradores são bilíngues, para poder atender de forma personalizada todos os clientes.
O COMÉRCIO: VOCÊS TAMBÉM POSSUEM UMA
FERRAMENTA DIGITAL DE ALTA TECNOLOGIA?
LABSTAR: Sim, o ‘GPS vascular’ ou ‘ultrassom de veias’, o VeinViewer, um visualizador de veia que utiliza luz infravermelha para detectar os vasos de pacientes que estejam até 10mm de profundidade, difíceis de encontrar através da visão e da palpação. O aparelho possui imagens em alta definição e reduz o número de punções nos pacientes.

O COMÉRCIO: SEU ATENDIMENTO OFERECE CONVÊNIOS?
LABSTAR: Atendemos praticamente todos os convênios, como Unimed, Bradesco, SulAmérica, Hapvida e os locais das funerárias São Francisco e Irmãos Pânico.

O COMÉRCIO: QUAIS AS CERTIFICAÇÕES QUE O LABORATÓRIO POSSUI?
LABSTAR: Temos como padrão de qualidade o Programa Nacional Controle de Qualidade (PNCQ) e estamos em fase de conclusão do ISO, que são as maiores certificações em termos laboratoriais. A responsabilidade técnica é da biomédica, Stella F. Rossetto Barros, formada há 10 anos, especialista em análises clínicas e sempre atuante na área.


serviço:
Rua Piedade, 266, no Centro - Lençóis Paulista (14) 3264-2005 e o (14) 9 8169-0909 (WhatsApp)

Um assunto que é considerado tabu, mas cujo debate pode ajudar pessoas a entenderem o sofrimento decorrente das situações vividas, as chamadas mães narcisistas está relacionado à um transtorno de personalidade, com agravante de que o narcisista não reconhece sua condição, o que impede seu tratamento. As explicações e a avaliação do quanto é importante abordar o tema é da psicanalista Luciene Moretto.

O abuso psicológico proporcionado pela mãe narcisista pode ser tão cruel que tem levado muitas vítimas a formarem grupos de apoio nas redes sociais para alertar quem está vivendo a situação sem ter consciência do problema.

Luciene explica que, por não reconhecer sua condição

e se sentir superior as demais pessoas, o narcisista, em geral, vai culpar aos outros por situações de conflito e vai tentar manipular aos que estão próximos, o que leva à uma relação muito difícil.
Mas, conviver com a mãe narcisista é muito mais doloroso, porque a sociedade tende a ter uma imagem intocável das mães. “Tem esse olhar de que uma mãe não vai querer o mal do filho e geralmente as filhas são as maiores vítimas”, comenta.
A psicanalista relata que uma das características da mãe narcisista é se sentir superior e por isso tratam os filhos com inferioridade. “Uma frase que elas usam muito é: você me deve a vida e só existe porque eu quis, outras vezes dizem que deveriam ter abortado. Ela fala coisas que agridem muito o ‘psicológico’”, lamenta.
A manipulação é outra característica, o que leva a filha a acreditar que nunca vai ser tão boa quanto sua mãe, o que
afeta sua autoestima. “Você nunca tem desta mãe o reconhecimento por algo positivo ou conquistado, é sempre muita crítica. E este é um círculo vicioso de sofrimento, porque a filha quer o amor desta mãe, mas sente que nunca será boa para merecê-lo”.
Os conflitos tendem a aumentar na adolescência. “Existe muito ciúmes. A mãe não suporta o fato de a filha fazer o que ela não pôde. Ela não deixa a filha viver a própria vida e não a encoraja” comenta.
O comportamento abusivo, no entanto, ocorre mais dentro de casa, já que socialmente a mãe valoriza e enaltece a filha, ao contrário do que faz no dia a dia. “Por isso é difícil identificar, porque ela faz o jogo de manter uma aparência social diferente, e se a filha diz que a mãe a maltrata, ninguém acredita. É abusivo e perverso para a vítima”, diz.
Outra perversidade, segundo Luciene, é que quando a mãe percebe que está perdendo seu objeto, no caso, a filha, muda o diálogo para manter o poder, se transformando em alguém dócil e carinhoso. A mãe também mente para manter as aparências que ela mesmo cria.

A mãe narcisista não admite ser questionada, quando a filha tenta uma conversa. Muitas vezes, a pune com o silêncio e rejeita a vítima, que sofre por não poder resolver a situação. “Isso é uma forma de abuso”, afirma. Infelizmente, de acordo com Luciene, por ser algo que afeta a vítima ao longo dos anos, muitas vezes, a única forma de cura para a vítima é o afastamento e a procura por ajuda “Este é um dos transtornos mais difíceis pelo que causa à vítima e ocorre com muita frequência, infelizmente”, avalia.
Para mais informações: https:// filhasdemaesnarcisistas.com.br https:// comosuperarmaesnarcisistas.com
serviço: Av. Nove de Julho, 972 – Centro - Lençóis Paulista Instituto Superos
R. Abrahão Rahal, 1-60 – Jd. América - Bauru
Telefones: (14) 99785-4884 | (14) 98119-9903


SINTOMAS PODEM LEVAR O PORTADOR A SER VISTO DE FORMA EQUIVOCADA
Segundo a Associação Brasileira do Déficit de Atenção (ABDA), o transtorno do déficit de atenção com hiperatividade (TDAH), é neurobiológico de causas genéticas, caracterizado por sintomas como falta de atenção, inquietação e impulsividade. Aparece na infância e pode acompanhar o indivíduo por toda a vida.
Amanda Nara Angélico Ribeiro é mãe de um adolescente que possui o transtorno. Nesta entrevista para a Revista O Comércio ela compartilha sua experiência para contribuir com mães e pais que possam passar pelos mesmos desafios impostos pelo TDAH.
Ela conta que o primeiro contato com o transtorno foi durante uma viagem a Belém do Pará, quando conheceu uma dentista cujo filho tem o TDAH. “Relatei algumas dificuldades que eu tinha com meu filho e ela me alertou sobre os sintomas e me presenteou com um livro sobre o assunto. Foi meu primeiro

contato. Como trabalho na área da Saúde, procurei informações com colegas. Procurei indicação de um profissional qualificado. Foi então que encontrei um neuropediatra e fechamos o diagnóstico”, contou.

Sobre os sintomas, ela lamenta o fato de que ainda são pouco relacionados ao transtorno. “Por conta da hiperatividade, meu filho ‘irritava’ facilmente colegas e familiares ao seu redor com movimentos repetitivos de objetos, como bater incessantemente tampas de potes, réguas ou lápis na carteira. Já fui até chamada no colégio quando ele estava na 4ª série para ser notificada de que sua régua tinha sido recolhida por estar atrapalhando a sala de aula. Quando eu ia ajudá-lo nas tarefas de casa era sempre uma briga, pois ele não conseguia focar, sempre trazia assuntos aleatórios. Hoje, é muito difícil falar com meu filho assuntos que demandam início, meio e fim. A atenção que ele dá é muito curta, ele se distrai facilmente”, explica. Amanda lamenta ainda o fato de o transtorno gerar situações difíceis para o portador, devido à falta de compreensão por parte da sociedade. “Meu filho é impulsivo demais, ele não consegue raciocinar os danos que certas atitudes podem ocasionar. Essa impulsividade levou à expulsão da escola. A equipe do colégio fez consciente de que ele tinha o transtorno, inclusive o colégio oferece apoio com psicóloga, que ao invés de acolher, o fez passar por episódios humilhantes. Foi traumático para ele e para mim”, lamenta.

Para lidar com a síndrome ela orienta: “É preciso dialogo e paciência. O mais importante foi eu conhecer sobre o transtorno
para melhor tratar meu filho, mas nem todos têm essa disponibilidade. Os desafios do TDAH são diários. O TDAH gera um comportamento que facilmente se confunde com teimosia, relaxo, desorganização, procrastinação, desatenção. Eu dou o apoio emocional que posso oferecer a ele, para que não perca o foco e consiga terminar tarefas iniciadas, pois este é só um transtorno que merece ser compreendido e acolhido”, afirma. Por sua experiência, a informação é o melhor caminho para
os pais que tenham filhos com sintomas semelhantes. “Busquem informações a respeito com especialistas como neurologistas, psiquiatras ou psicólogos. Há também livros ótimos que me ajudaram muito a enxergar meu filho com suas dificuldades mascaradas. Vejam seus filhos teimosos, preguiçosos, bagunceiros e chorões como pessoas que podem ter uma mente inquieta, que merece atenção, compreensão e ajuda para lidar com o turbilhão de pensamentos que o TDAH traz”, conclui.

fábio luiz vicente Psicólogo Clínico e Neuropsicólogo


Um dos mercados que mais cresce no Brasil é o mercado de games. O número de brasileiros que fazem uso de jogos eletrônicos já atingiu a marca de 74,5 % da população. Temos uma parcela importante da população que faz uso diariamente de celulares, videogames e computadores para jogar.
No entanto, segundo o Instituto de Psicologia da Universidade de São Paulo (USP), um em cada quatro adolescentes brasileiros faz uso excessivo de games. Quando o uso passa a causar desequilíbrios e sofrimento psíquico, podemos estar diante de um transtorno definido pela Organização Mundial da Saúde como: Transtorno de Videogame (TVG).
Como em qualquer transtorno mental, ele causa sofrimento e impacta no funcionamento da vida de crianças, adolescentes e adultos
de uma forma importante. Um dos primeiros sinais de alerta para esse transtorno, principalmente com o público adolescente, é quando ele deixa de sair de casa para outras atividades e socializar para jogar.
O vício é uma perda de controle e os seguintes sinais devem ser observados: a) falta de controle sobre o jogo (exemplo: grande frequência e dificuldades para terminar de jogar): b) crescimento da prioridade dada ao jogo, que passa a ter maior importância sobre outros interesses da vida; c) continuar ou aumentar a frequência de jogar, independente das consequências negativas (exemplo: queda de rendimento escolar, problemas de saúde devido ao longo período sentado, etc,).
Um outro parâmetro importante e, que também pode ajudar aos pais e responsáveis é a média de tempo recomendada pela
Sociedade Brasileira de Pediatria, para crianças e adolescentes ficarem na frente de telas: 0 a 2 anos (evitar a exposição sem necessidade); 2 a 5 anos (1 hora diária com supervisão); 6 a 10 anos (1 a 2 horas diárias com supervisão); 11 a 18 anos (2 a 3 horas diárias).

A realização desse diagnóstico deve ser feita por um profissional capacitado da área de saúde mental, e pede que esses comportamentos sejam observados em um período de pelo menos 12 meses. Entretanto, esse período pode ser diminuído quando todos critérios forem preenchidos e os prejuízos forem muito graves.
As consequência de um transtorno dessa natureza podem ser de várias ordens e, dentre elas, destacamos os transtornos de humor, de ansiedade, isolamento social e problemas de saúde decorrentes das alterações de sono e alimentação.
Durante o período da pandemia, não somente os adultos, mas principalmente as crianças e adolescentes tiveram um uso aumentado e, muitas vezes, descontrolado de telas, redes sociais e jogos. Dessa forma, todo cuidado é pouco. Fique sempre atento.
Sabemos da importância da vacinação contra a Covid 19 na vida das pessoas. Com a vinda da vacina conseguimos reduzir o número de casos, e o mais importante, reduzimos as hospitalizações, e também, as mortes causadas pelo SARS COV 2. E a vida começou a retornar para a sua normalidade. Pela primeira vez foram vacinadas milhares de pessoas ao mesmo tempo por todo o globo terrestre, durante a própria pandemia. E ainda várias doses de reforço foram necessárias para o controle do vírus que nos assolava.


O tempo começou a passar e vimos o surgimento das variantes e logo em seguida algumas subvariantes virais causando surtos ainda dentro da pandemia. Era comum em alguns países o surgimento destas, principalmente em locais onde a vacinação ou a dose de reforço não avançava.
As primeiras vacinas foram eficazes contra a cepa original do SARS COV 2, e agora, temos as vacinas bivalentes que protegem contra o vírus
original, e também contra a variante Ômicron e suas subvariantes. A ANVISA ( Agência Nacional de Vigilância Sanitária) aprovou dois imunizantes. Os dois são produzidos pela farmacêutica Pfizer, sendo que um é feito a partir da subvariante da Ômicron BA.1, e outro conta com informações das BA.4 e BA.5.
Essas vacinas são consideradas mais eficientes e atualizadas, pois protegem contra as variantes e subvariantes que possuem uma característica genética diferente do vírus inicial. Ainda reduzem a chance de casos graves e morte. Lembrando que as vacinas monovalentes exercem um papel importante, ainda vale a pena atualizar e receber a dose de reforço.
Entre os grupos prioritários para receber as vacinas bivalentes estão os imunossuprimidos e os indivíduos com mais de 60 anos, que passam por um processo de imunossenescência, ou seja, quando há uma queda natural da imunidade com o avanço da idade. Então fique atento nas datas que serão publicadas e mantenha as doses atualizadas.

PARA IR AO MERCADO OU PARTICIPAR DE EVENTOS, CAMINHADA AJUDA NO IDEAL DE MANTER-SE JOVEM, APESAR DA IDADE

Quem vê Atílio Antônio dos Santos andando pelas ruas de Lençóis Paulista ou dedica um tempinho para uma boa conversa não imagina que no último dia 13 de janeiro ele completou 89 anos. Disposição, lucidez e amor pela vida sobram para o ‘jovem idoso’, que há cerca de
quatro anos vem praticando caminhadas como forma de se divertir, fazer novos amigos e manter a saúde, e com isso, acumulado medalhas e troféus pelo desempenho nos eventos que participa.
Atílio nasceu em Ivaiporã, no Paraná, sendo o segundo de 11 irmãos, que enfrentaram as durezas da vida na roça e passaram por muitos desafios, que devem estar nas suas memórias que ele já começou a escrever. Do casamento de quase 60 anos com Antônia, que faleceu em 2019, nasceram André, Andreia, Adicéia e Admilson, e depois oito netos e dois bisnetos.
Desde que se tornou viúvo, o montador industrial aposentado deixou o Paraná e passou a se dividir entre Jundiaí e Lençóis Paulista, onde residem as filhas. Se fixou de vez aqui, há cerca de três anos, após ‘ficar preso’ na cidade, pela pandemia.
Sempre ativo, desde a juventude na época do futebol, e caminhando cerca três quilômetros diariamente para cumprir as tarefas da casa – como ir ao supermercado - começou a participar de eventos de competição de corrida que incluíam as caminhadas na programação.


Foram quatro em Lençóis e Macatuba, até agora. Mas, Seo Atílio não pretende parar. “Eu me sinto flutuando. Jovem mesmo. Me deito e me levanto sem dores. Vejo muitas pessoas com menos idade reclamando e fico aborrecido com essa atitude”, comentou.
Para tanto, conta com o apoio e incentivo da filha Adicéia, que há seis anos participa das competições de corrida até cinco quilômetros. “O mais gostoso de participar das caminhadas é que no dia seguinte não sinto nada, nenhuma dor. Fico impressionado comigo mesmo”, comemora
Atílio. Adicéia garante que o pai é um exemplo em todos os eventos que participa.
Além das caminhadas, Atílio é assíduo frequentador da hidroginástica em um clube da cidade. Mais do que a atividade física, os fortes laços de amizade feitos em tão pouco tempo são fundamentais para manter a saúde física, mental e psicológica. De acordo com o aposentado, todos se divertem muito, enquanto fazem exercícios.

O ‘jovem idoso’ também acumula aventuras que sua condição física e psicológica proporciona, como quando voltava de uma viagem à Itália, depois de uma visita ao filho, e fez uma ponte aérea em Paris, em um dos maiores e mais movimentados aeroportos do mundo. Era a época da pandemia, e ele teve que fazer a conexão sozinho, sem entender o idioma local. “Fui o primeiro a sentar no avião”, comemora.
A sua boa condição, segundo ele, também é resultado do que a profissão proporcionou, que foi viajar por todo Brasil. Mas, Atílio tem uma receita que o ajuda a se sentir bem e manter saudável. “É preciso viver a vida e se sentir jovem, não se entregar porque ficou velho”, ensina.
COQUETEL VILA SPRING
INGREDIENTES
5 folhas de manjericão
50 ml de vodka
25 ml de xarope de tangerina
15 ml de suco de limão siciliano
1 Sprite®
1 Laranja Bahia
MODO DE PREPARO
Bata todos os ingredientes (exceto a Sprite® e as folhas de manjericão) em uma coquetelaria com muito gelo. Coe para um copo alto com muito gelo (o gelo da coqueteleira deve ser descartado) e complete com a Sprite®. Decore com um um twist de laranja Bahia e um ramo de manjericão.
O CARNAVAL CHEGOU E COM ELE A VONTADE DE FESTEJAR COM OS AMIGOS. ENTÃO, AQUI VÃO ALGUMAS DICAS DE DRINKS REFRESCANTES, QUE PODEM ANIMAR AINDA MAIS A FESTA, DESDE QUE CONSUMIDOS COM MODERAÇÃO
CAIPIROSKA DE LIMÃO DE LIQUIDIFICADOR


INGREDIENTES
2 limões
1 colher (sopa) de açúcar
1 dose de vodca (50ml)
Gelo a gosto
MODO DE PREPARO
Corte e separe 5 rodelas finas de um limão. Bata o restante do limão espremido no liquidificador com o açúcar, a vodca e gelo, até homogeneizar. Coloque em um copo e decore com as rodelas de limão reservadas. Sirva.


MAQUIAGEM CARNAVAL: Como estão os preparativos da folia de Carnaval 2023? Se você ainda não sabe qual maquiagem vai usar no bloquinho, nós separamos alguns exemplos de makes com muitas cores, glitter e tudo o que tem direito!
SE INSPIRE E CAIA NA FOLIA COM MUITA COR E ESTILO!
MAQUIAGEM PARA O CARNAVAL 2023: Essa é uma época do ano que pede duas coisas: cores e muito glitter, e pensando nisso, nós selecionamos as mais lindas makes de carnaval para você sambar muito e arrasar na produção!
Em um tempo em que tudo fica mais liberal e divertido, sua maquiagem para o Carnaval 2023 precisa contar com bastante cor e brilho. Seja para compor a sua fantasia, seja para usar como marca principal do seu look, a maquiagem deve ser muito bem feita.
MAKES PARA CARNAVAL COM GLITTER 2023


Se engana quem pensa que a maquiagem para o Carnaval com glitter se limita ao canto dos olhos. Na verdade, há possibilidades





bem diversificadas e legais para usar o acessório na sua make. Aproveite e use e abuse do glitter nas suas makes!


 DICAS DA MOYA
fernanda moya Maquiadora e proprietária do Fernanda Moya Studio Princess
DICAS DA MOYA
fernanda moya Maquiadora e proprietária do Fernanda Moya Studio Princess

Com a mudança de gestão à frente do Governo Federal no início do corrente ano, identificamos um aumento incomum na procura de informações acerca da chamada “Holding Familiar” por pessoas interessadas em proteger o seu patrimônio.
Ao tentar entender melhor esse fenômeno, identificamos que a ampla divulgação de um trecho isolado da entrevista concedida no dia 10/05/2021 pelo atual Ministro da Fazenda (quando ainda era pré-candidato ao Governo do Estado de São Paulo nas últimas eleições), pode ter sido a razão principal do aumento de interesse no tema em questão.
No referido trecho da entrevista Haddad aparece dizendo que “entre uma geração e outra, o socialista acha que tem que ter uma correção. E essa correção é tributar a herança. Sim, você acumula a tua grana. Só que você não vai, o Jeff Bezos não vai deixar quarenta bilhões de dólares para cada filho.
O estado tem o direito e até o dever de fazer com que o filho do Jeff Bezos tenha algum trabalho na vida, né? Não seja um parasita da sociedade. Então a ideia é que você mitigue as desigualdades sociais de uma geração para outra a partir de uma lógica redistributiva”.
Mas o que a Holding Familiar tem a ver com todo esse contexto? Simples! Ela é uma modalidade muito eficiente de planejamento sucessório. Em resumo, trata-se de uma empresa criada com a finalidade de facilitar a perpetuação e transferência do patrimônio de uma família aos seus herdeiros.
Essa empresa (pessoa jurídica), cujo capital social é integralizado pelo patrimônio da família (bens móveis, imóveis, cotas de empresas, etc), organiza-se em cotas ou ações, sendo que cada herdeiro tem sua quantidade de cotas/ações definidas em um contrato social. Com isso, todos os bens da família
são transformados em patrimônio líquido e cada integrante possui um percentual (cota).

A premissa básica é evitar o processo de inventário quando do falecimento do titular do patrimônio, evitando também a tributação respectiva (Imposto de Transmissão Causa Mortis). Sabe-se que na maioria das vezes o processo de inventário é extremamente demorado e oneroso acarretando, via de regra, a necessidade em promover a venda de algum bem para cobrir os seus custos.

Existem inúmeras vantagens ao se criar uma Holding Familiar, dentre as quais destacamos: vantagem tributária; proteção do patrimônio; planejamento sucessório; e melhor administração dos bens familiares.
Em razão da importância e extensão do assunto, continuaremos tratando desse tema no artigo do próximo mês, detalhando suas vantagens e apresentando as eventuais desvantagens.
Desde já, reforçamos que para obter maiores informações sobre Holding Familiar você pode procurar um advogado ou contador da sua confiança, o qual poderá apresentar um planejamento específico para o seu contexto patrimonial.
Dr. PETERSON LUIZ VON HOLLEBEN Advogado inscrito na OAB/SP sob nº 479.824. Especialista em Direito Privado e Empreendedorismo pela ISAE/FGV. Dra. MARIANA VALE DE NORONHA VON HOLLEBEN Advogada inscrita na OAB/SP sob nº 481.086. Especialista em Direito Aplicado pela Escola da Magistratura. Sócios do Escritório Noronha & Holleben – Advogados.








